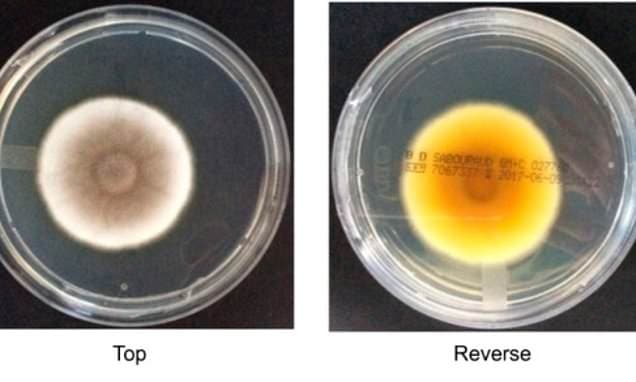
The fungus that could contaminate Mars: Scientists discover spore that can survive trip to the Red Planet - and NASA's ultra-sanitised cleanrooms aren't enough to stop it

Scientists have long known that fungi are resilient, but research suggests some strains might even survive the long, brutal trip to Mars.
The fungus that could contaminate Mars: Scientists discover spore that can survive trip to the Red Planet - and NASA's ultra-sanitised cleanrooms aren't enough to stop it
Daily Mail·Daily Mail··1 min read
D
Continue reading on Daily Mail
This article was sourced from Daily Mail's RSS feed. Visit the original for the complete story.